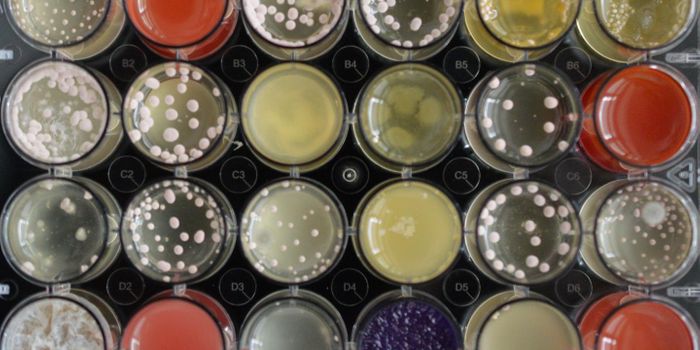
Fungal Metabolite Reduces Antibiotic Resistance

Antimicrobial Resistance
Antimicrobial resistance (AMR) is the ability of microbes, including bacteria, viruses, and some parasites, to resist the effects of drugs, meaning that the germs are not only not killed, but there their growth is not inhibited. For obvious reasons, infections with resistant organisms are difficult to treat, requiring costly and sometimes toxic alternatives. While some people are at increased risk, no single person can avoid the risk of antibiotic-resistant infections altogether. Since organisms will always find a way to adapt and resist antibiotics, there is a heightened need to keep new resistance from developing and to prevent the resistance that already exists from spreading.
-
APR 16, 2017VideosAntimicrobial resistance is not only a growing health threat, it's already a huge problem; it just doesn't get much atte ...Written By: Carmen LeitchAPR 06, 2017Clinical & Molecular DXDiagnosing an infection as bacterial or viral can be difficult, even for trained specialists. And while it may seem sens ...MAR 05, 2017MicrobiologyAlarm bells have been ringing all over the world about drug-resistant superbugs, which are expected to pose a huge threa ...Written By: Carmen LeitchFEB 22, 2017MicrobiologyAs if Komodo dragons weren’t cool enough, a new study reports that these guys have antimicrobial proteins in their ...Written By: Kerry EvansFEB 07, 2017Cell & Molecular BiologyA new antibiotic, teixobactin, was identified a few years ago. It can kill bacteria and has not been shown resistance by ...Written By: Carmen LeitchJAN 07, 2017MicrobiologyThe antibacterial properties of heavy metals have been appreciated for some time, but how the heck do they work? This so ...Written By: Kerry EvansDEC 06, 2016MicrobiologyAn antibiotic resistance gene that was known to be present in animals on farms in Europe and Asia has now been found in ...Written By: Carmen LeitchNOV 21, 2016MicrobiologyAntibiotic resistant bacteria are becoming more common, and researchers have now discovered minute levels of resistant m ...Written By: Carmen LeitchNOV 19, 2016MicrobiologyRising antibiotic resistance is considered a major public health threat; one that the United Nations has taken notice of ...Written By: Carmen LeitchSEP 12, 2016MicrobiologyResearchers at MIT have created a new device that allows for the measurement of the growth rate of many individual cells ...Written By: Carmen LeitchSEP 09, 2016Genetics & GenomicsThe Food and Drug Administration (FDA) announced earlier this month that they would be banning 19 antimicrobial chemical ...Written By: Kara MarkerAUG 16, 2016ImmunologyYour stomach growls and you think, “it’s telling me that it’s time for lunch.” However, it&rsquo ...Written By: Kara MarkerJUL 17, 2016MicrobiologyResearchers can stimulate fungi to produce antimicrobial compounds, and in doing so they have detected a novel one. The ...Written By: Carmen LeitchJUL 12, 2016MicrobiologyEarlier this year, it was announced that a so-called superbug had been detected in a patient in the United States. Now, ...Written By: Carmen LeitchJUL 05, 2016ImmunologyWith the growth of superbug populations growing all the time, researchers are desperately looking for ways to reduce the ...Written By: Kara MarkerJUN 13, 2016MicrobiologyA new material has been created by researchers in Singapore that kills E. coli bacteria in 30 seconds. As antibiotic res ...Written By: Carmen LeitchMAY 26, 2016MicrobiologyIn March 2015, President Obama released The National Action Plan for Combating Antibiotic-Resistant Bacteria. It is inte ...Written By: Carmen LeitchOCT 29, 2015MicrobiologyThe problem with antibiotics is that bacteria become resistant. Researchers at the University of Illinois at Urban ...Written By: Kerry EvansJUL 24, 2015MicrobiologyAntibiotics keep farm animals healthy and promote their growth, but excessive antibiotic use no doubt contributes to ant ...Written By: Kerry EvansJUL 07, 2015Health & MedicineAntimicrobial resistance has been recognized as a significant global health priority that threatens to take modern medic ...Written By: Sarah HertrichMAR 17, 2015Genetics & GenomicsMany animals, including humans, acquired essential ‘foreign' genes from microorganisms co-habiting their environment in ...Written By: Ilene SchneiderMAR 04, 2015Cell & Molecular BiologyEvolution brings improvements, but it's also a hotbed for lots of diseases that defy treatment.
We see this i ...Written By: Judy O'RourkeFEB 08, 2014VideosAntimicrobial resistance (AMR) is resistance of a microorganism to an antimicrobial medicine to which it was previously ...Written By: Jennifer Ellis
APR 16, 2017
Videos
Antimicrobial resistance is not only a growing health threat, it's already a huge problem; it just doesn't get much atte
...
Written By:
Carmen Leitch
APR 06, 2017
Clinical & Molecular DX
Diagnosing an infection as bacterial or viral can be difficult, even for trained specialists. And while it may seem sens
...
MAR 05, 2017
Microbiology
Alarm bells have been ringing all over the world about drug-resistant superbugs, which are expected to pose a huge threa
...
Written By:
Carmen Leitch
FEB 22, 2017
Microbiology
As if Komodo dragons weren’t cool enough, a new study reports that these guys have antimicrobial proteins in their
...
Written By:
Kerry Evans
FEB 07, 2017
Cell & Molecular Biology
A new antibiotic, teixobactin, was identified a few years ago. It can kill bacteria and has not been shown resistance by
...
Written By:
Carmen Leitch
JAN 07, 2017
Microbiology
The antibacterial properties of heavy metals have been appreciated for some time, but how the heck do they work? This so
...
Written By:
Kerry Evans
DEC 06, 2016
Microbiology
An antibiotic resistance gene that was known to be present in animals on farms in Europe and Asia has now been found in
...
Written By:
Carmen Leitch
NOV 21, 2016
Microbiology
Antibiotic resistant bacteria are becoming more common, and researchers have now discovered minute levels of resistant m
...
Written By:
Carmen Leitch
NOV 19, 2016
Microbiology
Rising antibiotic resistance is considered a major public health threat; one that the United Nations has taken notice of
...
Written By:
Carmen Leitch
SEP 12, 2016
Microbiology
Researchers at MIT have created a new device that allows for the measurement of the growth rate of many individual cells
...
Written By:
Carmen Leitch
SEP 09, 2016
Genetics & Genomics
The Food and Drug Administration (FDA) announced earlier this month that they would be banning 19 antimicrobial chemical
...
Written By:
Kara Marker
AUG 16, 2016
Immunology
Your stomach growls and you think, “it’s telling me that it’s time for lunch.” However, it&rsquo
...
Written By:
Kara Marker
JUL 17, 2016
Microbiology
Researchers can stimulate fungi to produce antimicrobial compounds, and in doing so they have detected a novel one. The
...
Written By:
Carmen Leitch
JUL 12, 2016
Microbiology
Earlier this year, it was announced that a so-called superbug had been detected in a patient in the United States. Now,
...
Written By:
Carmen Leitch
JUL 05, 2016
Immunology
With the growth of superbug populations growing all the time, researchers are desperately looking for ways to reduce the
...
Written By:
Kara Marker
JUN 13, 2016
Microbiology
A new material has been created by researchers in Singapore that kills E. coli bacteria in 30 seconds. As antibiotic res
...
Written By:
Carmen Leitch
MAY 26, 2016
Microbiology
In March 2015, President Obama released The National Action Plan for Combating Antibiotic-Resistant Bacteria. It is inte
...
Written By:
Carmen Leitch
OCT 29, 2015
Microbiology
The problem with antibiotics is that bacteria become resistant. Researchers at the University of Illinois at Urban
...
Written By:
Kerry Evans
JUL 24, 2015
Microbiology
Antibiotics keep farm animals healthy and promote their growth, but excessive antibiotic use no doubt contributes to ant
...
Written By:
Kerry Evans
JUL 07, 2015
Health & Medicine
Antimicrobial resistance has been recognized as a significant global health priority that threatens to take modern medic
...
Written By:
Sarah Hertrich
MAR 17, 2015
Genetics & Genomics
Many animals, including humans, acquired essential ‘foreign' genes from microorganisms co-habiting their environment in
...
Written By:
Ilene Schneider
MAR 04, 2015
Cell & Molecular Biology
Evolution brings improvements, but it's also a hotbed for lots of diseases that defy treatment.
We see this i ...
We see this i ...
Written By:
Judy O'Rourke
FEB 08, 2014
Videos
Antimicrobial resistance (AMR) is resistance of a microorganism to an antimicrobial medicine to which it was previously
...
Written By:
Jennifer Ellis